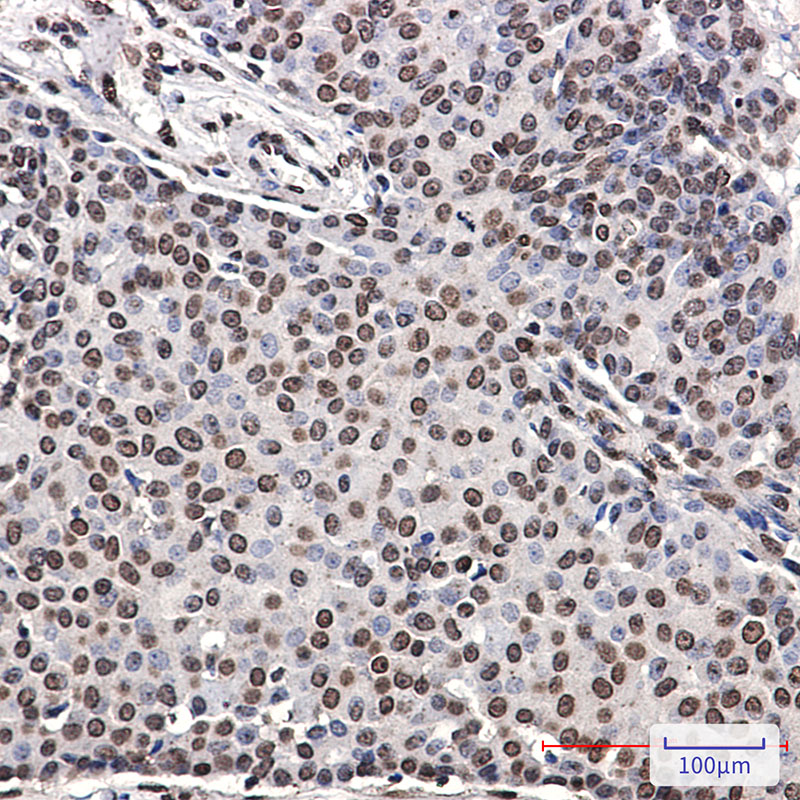

-
分类: 科研抗体货号: P20169别名: CAS; p120; BCDS2; CTNND; P120CAS; P120CTN; p120(CAS); p120(CTN)应用: WB,IHC,IF反应种属: Human,Mouse
-
分类: 科研抗体货号: P20168别名: CAS; p120; BCDS2; CTNND; P120CAS; P120CTN; p120(CAS); p120(CTN)应用: WB反应种属: Human,Mouse
-
分类: 科研抗体货号: P20187别名: MET; Hepatocyte growth factor receptor; HGF receptor; HGF/SF receptor; Proto-oncogene c-Met; Scatter factor receptor; SF receptor; Tyrosine-protein kinase Met应用: WB,IP反应种属: Human
-
分类: 科研抗体货号: P20167别名: CCNB1; CCNB; G2/mitotic-specific cyclin-B1应用: WB,IP反应种属: Human
-
分类: 科研抗体货号: P20174别名: ERBB4; HER4; Receptor tyrosine-protein kinase erbB-4; Proto-oncogene-like protein c-ErbB-4; Tyrosine kinase-type cell surface receptor HER4; p180erbB4应用: WB,IP,IHC反应种属: Human
-
分类: 科研抗体货号: P20185别名: MCM2; BM28; CCNL1; CDCL1; KIAA0030; DNA replication licensing factor MCM2; Minichromosome maintenance protein 2 homolog; Nuclear protein BM28应用: WB,IP,IHC,IF反应种属: Human
-
分类: 科研抗体货号: P20166别名: CDK2; CDKN2; Cyclin-dependent kinase 2; Cell division protein kinase 2; p33 protein kinase应用: WB,IP,IHC反应种属: Human
-
分类: 科研抗体货号: P20173别名: EIF-4B; PRO1843应用: WB,IHC反应种属: Human,Mouse,Rat
-
分类: 科研抗体货号: P20184别名: JUN; Transcription factor AP-1; Activator protein 1; AP1; Proto-oncogene c-Jun; V-jun avian sarcoma virus 17 oncogene homolog; p39; JUND; Transcription factor jun-D应用: WB,IP反应种属: Human,Mouse,Rat
-
分类: 科研抗体货号: P20165别名: CDKN2; p33(CDK2)应用: WB,IP,IHC反应种属: Human

鄂公网安备42018502007531号
鄂公网安备42018502007531号

